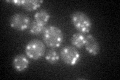
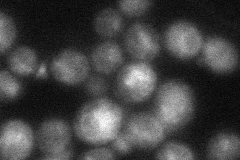
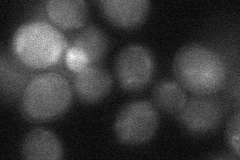
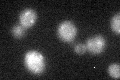

View description
Alpha1,2-mannosyltransferase of the Golgi involved in protein mannosylation
Localization:
Intensity:
Fold change:
Significance:
-
C’ GFP library in SD
punctate38.07 -
N' NOP1pr-GFP in SD

punctate,vacuole membrane179.604 -
N' TEF2pr-mCherry in SD

ER,vacuole311.96 -
N' NATIVEpr-GFP in SD
vacuole32.9191 -
N' TEF2pr-VC and Cyto-VN in SD
below threshold27.2789 -
C’ GFP library in SD+DTT

punctate21.750.57Yes -
C’ GFP library in SD+H2O2
punctate24.340.63Yes -
C’ GFP library in Starvation Media

punctate33.240.87No -
C’ GFP library on the background of Pup2-DaMP

punctate -
C’ GFP library on the background of CCT mutant

punctate34.97340.918402No
